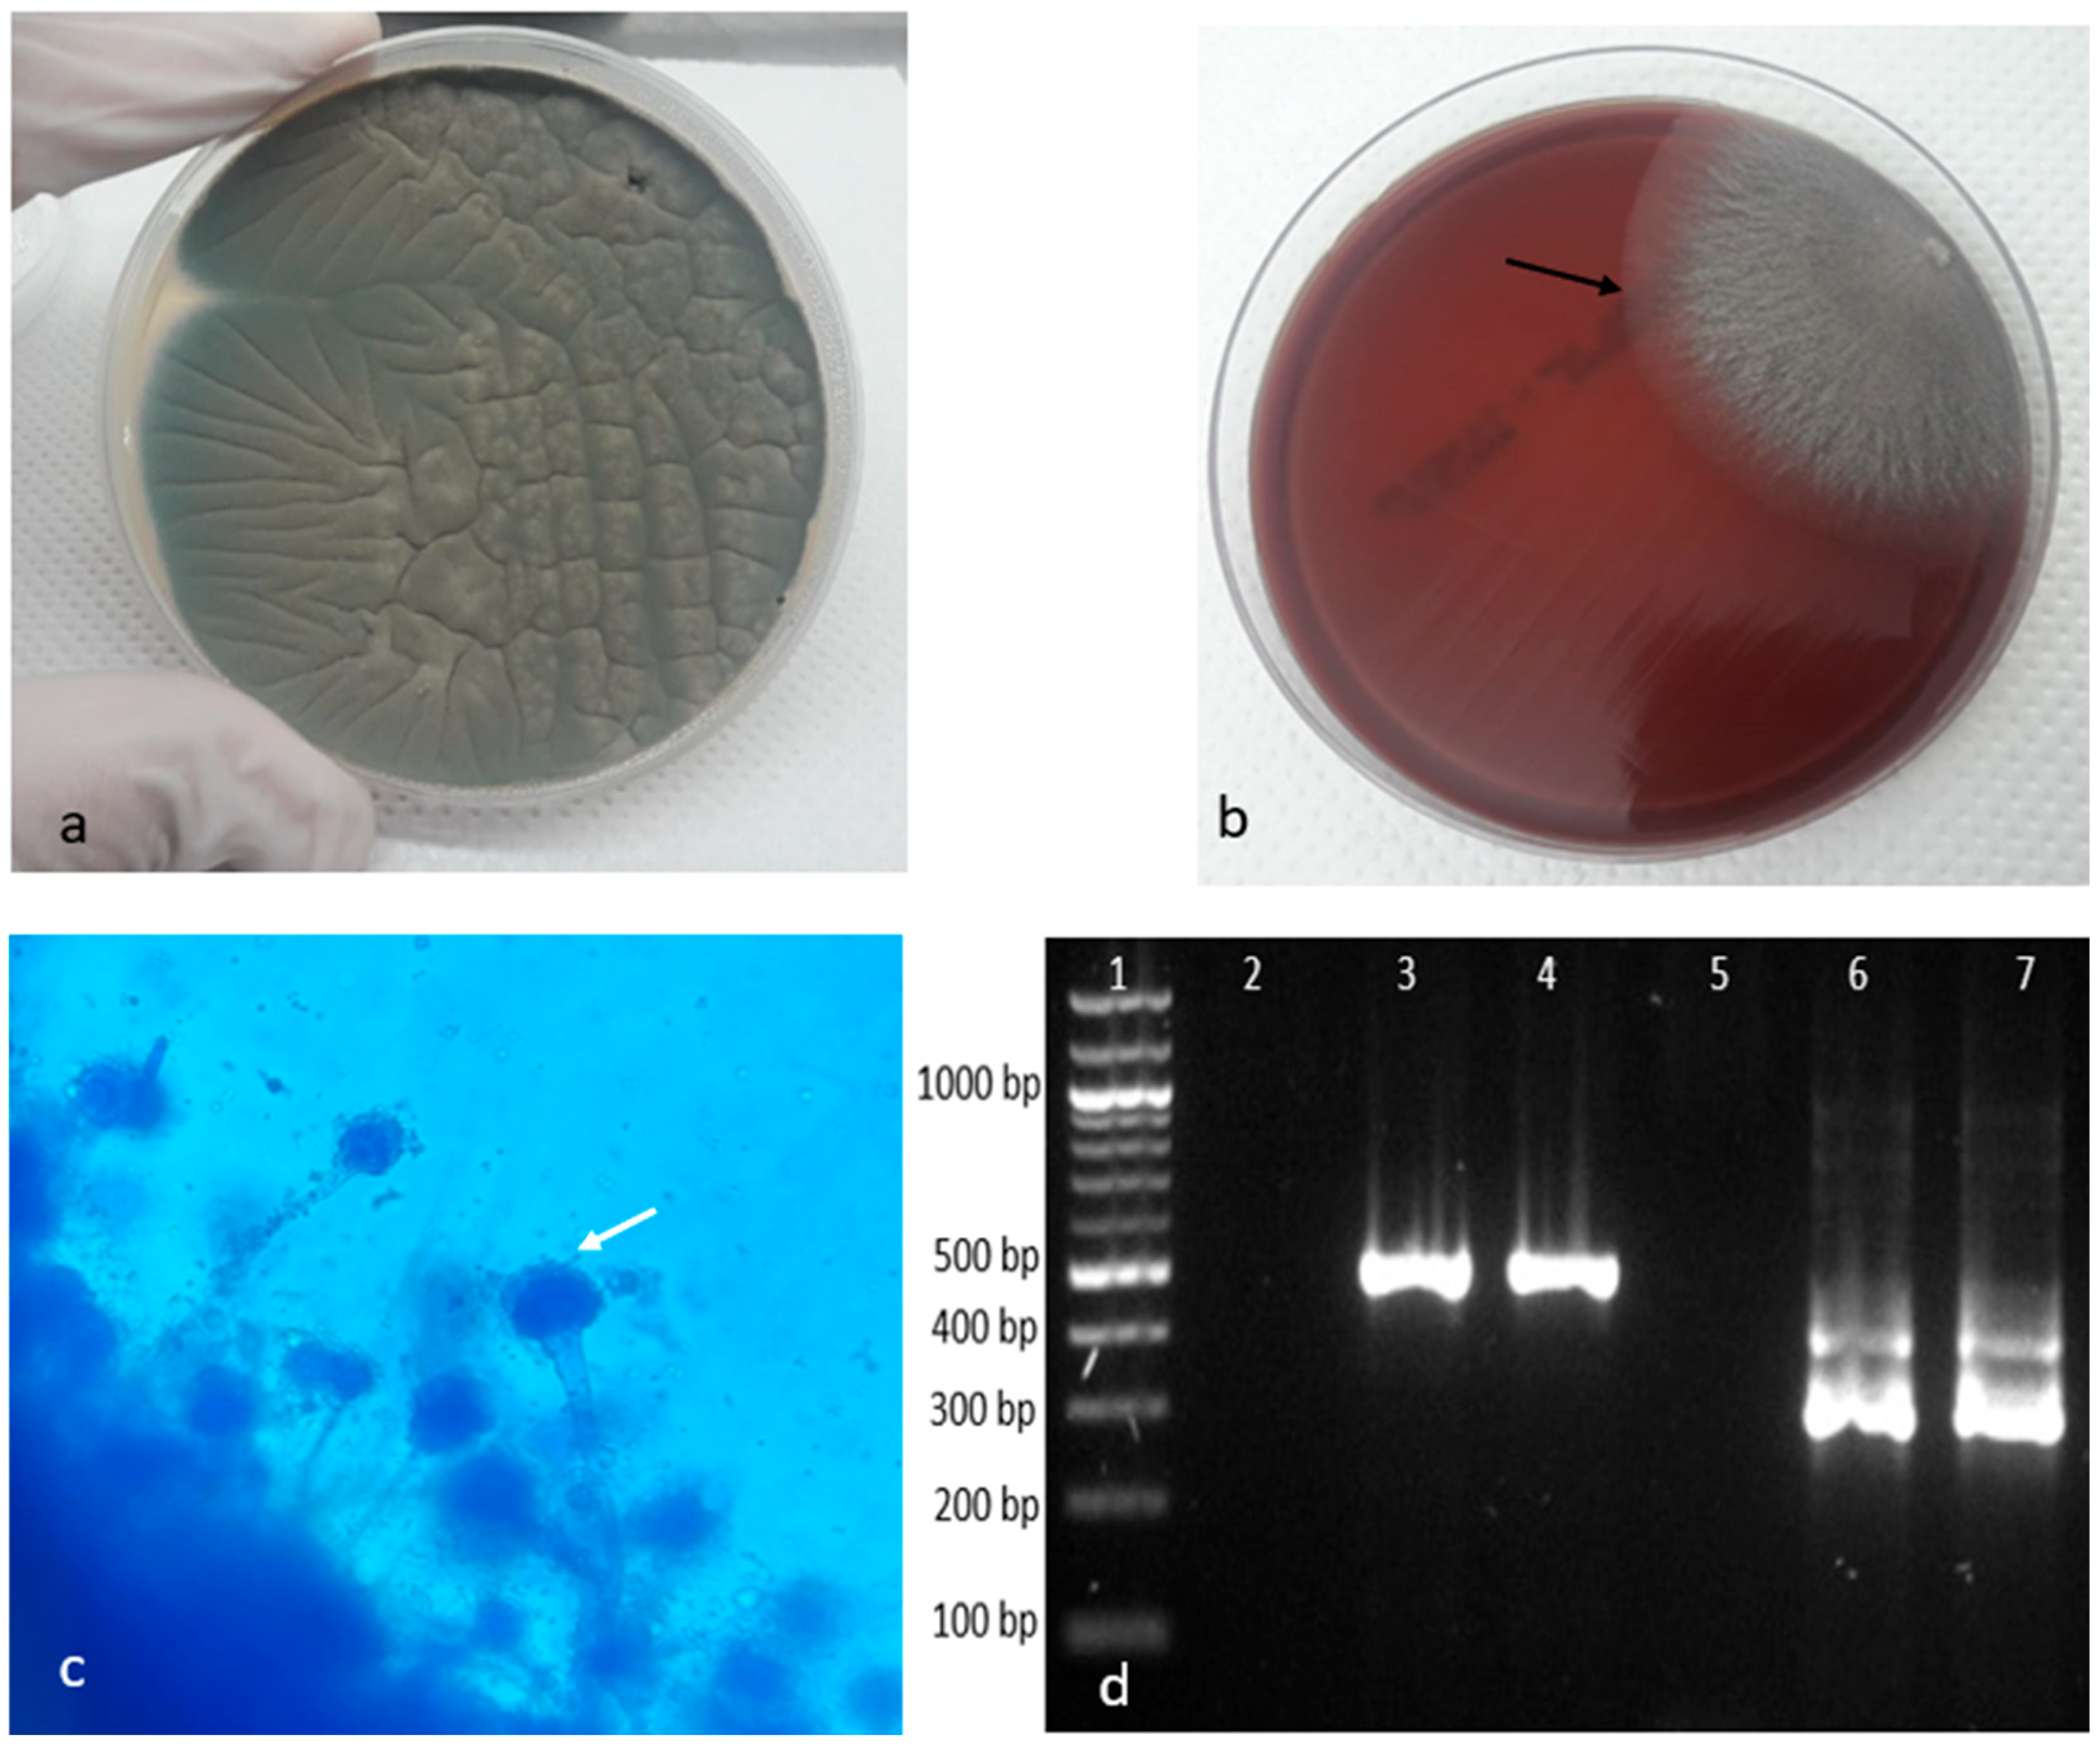
Animals 14 02282 g004

Disseminated Infection with Aspergillus fumigatus in a Scarlet Macaw Parrot (Ara macao)—A Case Report
Abstract
Simple Summary
Abstract
1. Introduction
2. Materials and Methods
2.1. Case Description
2.2. Isolation and Identification of Aspergillus spp.
3. Results
4. Discussion
5. Conclusions
Author Contributions
Funding
Institutional Review Board Statement
Informed Consent Statement
Data Availability Statement
Acknowledgments
Conflicts of Interest
References
- Arné, P.; Risco-Castillo, V.; Jouvion, G.; Barzic, C.L.; Guillot, J. Aspergillosis in wild birds. J. Fungi 2021, 7, 241. [Google Scholar] [CrossRef] [PubMed]
- Tell, L.A. Aspergillosis in mammals and birds: Impact on veterinary medicine. Med. Mycol. 2005, 43 (Suppl. S1), S71–S73. [Google Scholar] [CrossRef] [PubMed]
- Oglesbee, B.L. Mycotic diseases. In Avian Medicine and Surgery, 1st ed.; Altman, R.B., Chubb, S.L., Dorrestein, G.M., Quesenberry, K., Eds.; Publisher Saunders Company: Philadelphia, PA, USA, 1997; pp. 323–361. [Google Scholar]
- De Oca, V.M.; Martínez, S.E.V.; Salinas, E.M.; Roberto, E.O.; Sánchez-Godoy, F. Pathological and mycological characterization of pulmonary Aspergillus fumigatus infection producing gliotoxin in a captive African grey parrot (Psittacus erithacus). Braz. J. Vet. Pathol. 2022, 15, 93–98. [Google Scholar] [CrossRef]
- Maina, J.N. The Lung-Air Sac System of Birds: Development, Structure, and Function, 1st ed.; Springer: Berlin/Heidelberg, Germany; New York, NY, USA, 2005; pp. 159–174. [Google Scholar] [CrossRef]
- Hauck, R.; Cray, C.; França, M. Spotlight on avian pathology: Aspergillosis. Avian Pathol. 2020, 49, 115–118. [Google Scholar] [CrossRef] [PubMed]
- Kaplan, W.; Arnstein, P.; Ajello, L.; Chandler, F.; Watts, J.; Hicklin, M. Fatal aspergillosis in imported parrots. Mycopathologia 1975, 56, 25–29. [Google Scholar] [CrossRef] [PubMed]
- Burr, E.W. Enzootic aspergillosis in wild red vented cockatoos in the Philippines. Mycopathologia 1981, 73, 21–28. [Google Scholar] [CrossRef] [PubMed]
- Churria, C.D.G.; Reynaldi, F.; Origlia, J.; Marcantoni, H.; Píscopo, M.V.; Loyola, M.; Reinoso, E.H.; Petruccelli, M. Pulmonary aspergillosis due to Aspergillus flavus infection in a captive Eclectus Parrot (Eclectus roratus). Braz. J. Vet. Pathol. 2012, 5, 4–6. [Google Scholar]
- Mihaylov, G.; Petrov, V.; Marutsov, P.; Simeonov, R.; Simeonova, G. A case of aspergillosis in a bearded vulture (Gypaetos barbatus). Trakia J. Sci. 2008, 6, 144–146. [Google Scholar]
- Cacciuttolo, E.; Rossi, G.; Nardoni, S.; Legrottaglie, R.; Mani, P. Anatomopathological aspects of avian aspergillosis. Vet. Res. Commun. 2009, 33, 521–527. [Google Scholar] [CrossRef] [PubMed]
- Latgé, J.P. Aspergillus fumigatus and aspergillosis. Clin. Microbiol. Rev. 1999, 12, 310–350. [Google Scholar] [CrossRef] [PubMed]
- Thom, C.; Raper, K.B. A Manual of the Aspergilli; The Williams & Wilkins Company: Baltimore, MD, USA, 1945; pp. 148–155. [Google Scholar]
- Sugita, C.; Makimura, K.; Uchida, K.; Yamaguchi, H.; Nagai, A. PCR identification system for the genus Aspergillus and three major pathogenic species: Aspergillus fumigatus, Aspergillus flavus and Aspergillus niger. Med. Mycol. 2004, 42, 433–437. [Google Scholar] [CrossRef] [PubMed]
- Souza, L.R.; Santana, C.H.; Ribeiro, L.N.; Sousa, D.R.; Gomes, K.M.C.; Barroca, J.M.J.F.; Silva, M.B.G.; Santos, R.L. Pneumonia, airsacculitis and osteomyelitis caused by Aspergillus fumigatus in an African grey parrot (Psittacus erithacus)–case report. Arq. Bras. Med. Vet. Zootec. 2024, 76, 269–274. [Google Scholar] [CrossRef]
- Arné, P.; Thierry, S.; Wang, D.; Deville, M.; Le Loc’h, G.; Desoutter, A.; Féménia, F.; Nieguitsila, A.; Huang, W.; Chermette, R.; et al. Aspergillus fumigatus in poultry. Int. J. Microbiol. 2011, 2011, 1–14. [Google Scholar] [CrossRef] [PubMed]
- Talbot, J.J.; Thompson, P.; Vogelnest, L.; Barrs, V.R. Identification of pathogenic Aspergillus isolates from captive birds in Australia. Med. Mycol. 2018, 56, 1038–1041. [Google Scholar] [CrossRef] [PubMed]
- Barton, J.T.; Daft, B.M.; Read, D.H.; Kinde, H.; Bickford, A.A. Tracheal aspergillosis in 6 1/2-week-old chickens caused by Aspergillus flavus. Avian Dis. 1992, 36, 1081–1085. [Google Scholar] [CrossRef] [PubMed]
- Beernaert, L.A.; Pasmans, F.; Van Waeyenberghe, L.; Haesebrouck, F.; Martel, A. Aspergillus infections in birds: A review. Avian Pathol. 2010, 39, 325–331. [Google Scholar] [CrossRef] [PubMed]
- Singh, R.; Singh, G.; Urhekar, A.D. Detection of Aspergillus Species by polymerase chain reaction. Int. J. Curr. Microbiol. Appl. Sci. 2016, 5, 254–260. [Google Scholar] [CrossRef][Green Version]

Disclaimer/Publisher’s Note: The statements, opinions and data contained in all publications are solely those of the individual author(s) and contributor(s) and not of MDPI and/or the editor(s). MDPI and/or the editor(s) disclaim responsibility for any injury to people or property resulting from any ideas, methods, instructions or products referred to in the content. |
© 2024 by the authors. Licensee MDPI, Basel, Switzerland. This article is an open access article distributed under the terms and conditions of the Creative Commons Attribution (CC BY) license (https://creativecommons.org/licenses/by/4.0/).
Share and Cite
Tanase, O.I.; Pavel, G.; Hritcu, O.M.; Dascalu, M.A.; Bratuleanu, B.E.; Rimbu, C.M.; Bocaneti, F.D. Disseminated Infection with Aspergillus fumigatus in a Scarlet Macaw Parrot (Ara macao)—A Case Report. Animals 2024, 14, 2282. https://doi.org/10.3390/ani14152282
Tanase OI, Pavel G, Hritcu OM, Dascalu MA, Bratuleanu BE, Rimbu CM, Bocaneti FD. Disseminated Infection with Aspergillus fumigatus in a Scarlet Macaw Parrot (Ara macao)—A Case Report. Animals. 2024; 14(15):2282. https://doi.org/10.3390/ani14152282
Chicago/Turabian StyleTanase, Oana Irina, Geta Pavel, Ozana Maria Hritcu, Mihaela Anca Dascalu, Bianca Elena Bratuleanu, Cristina Mihaela Rimbu, and Florentina Daraban Bocaneti. 2024. "Disseminated Infection with Aspergillus fumigatus in a Scarlet Macaw Parrot (Ara macao)—A Case Report" Animals 14, no. 15: 2282. https://doi.org/10.3390/ani14152282
APA StyleTanase, O. I., Pavel, G., Hritcu, O. M., Dascalu, M. A., Bratuleanu, B. E., Rimbu, C. M., & Bocaneti, F. D. (2024). Disseminated Infection with Aspergillus fumigatus in a Scarlet Macaw Parrot (Ara macao)—A Case Report. Animals, 14(15), 2282. https://doi.org/10.3390/ani14152282

